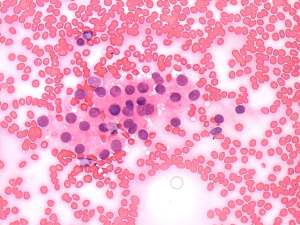

Papillary carcinoma - Case 9. |
|
Clinical data: a 51-year-old woman was referred for a follow-up evaluation of a nodular goiter. We examined the patient for the first time 5 years ago because of a 'lump in the throat' feeling and found multiple hypoechogenic lesions within the left thyroid including sonographically suspicious one, as well. At this time the patient refused aspiration cytology.
Palpation: no abnormality.
Functional state: euthyroidism (TSH-level 2.27 mIU/L).
Ultrasonography: the thyroids were echonormal. There were two hypoechoegenic nodules next to each other in the left lobe. The upper had regular shape and presented a type 2 vascular pattern while the lower one had irregular borders, contained microcalcifications. The volume of the former nodule increased by 38% and the latter suspicious one by 72% over the previous 5 years.
Cytological diagnosis (from the irregular nodule): papillary cancer.
Histopathology: three distinct entities - a papillary microcarcinoma with a maximal diameter of 9 mm according to the nodule aspirated, an oxyphilic adenoma according to the other nodule and several hyperplastic nodules in both thyroids.
Comment: it is worth comparing the differences in the staining methods. Nuclear details of smears stained by Pap-method are more unequivocal than those stained with hematoxylin-eosin.